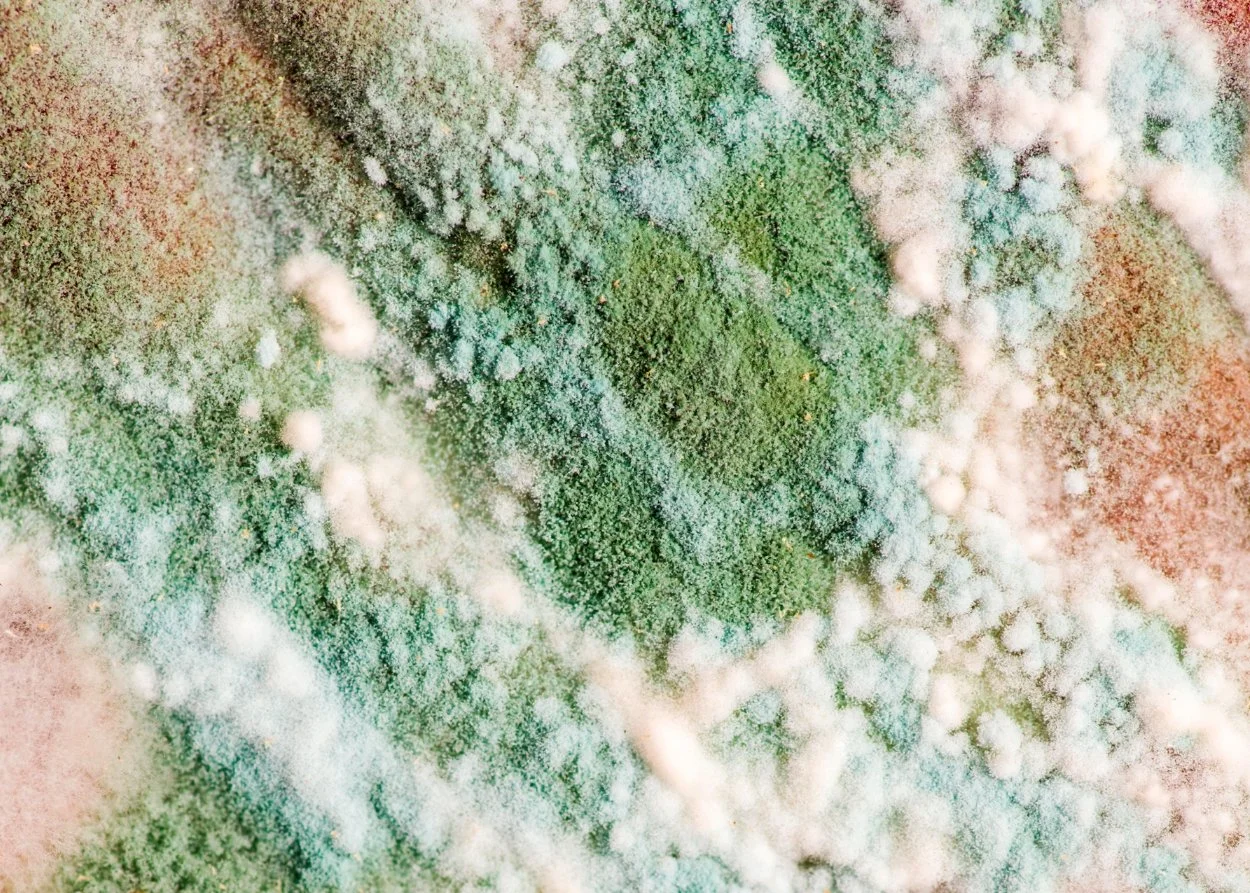

Certified experts with 15+ years experience providing mold testing, remediation, and environmental cleanup you can trust.
Family Owned Service
With trusted certification and 15 years of experience, our team delivers professional mold testing, inspection, remediation, and environmental cleanup solutions tailored to restore and protect your environment.
🌿 Free inspections for every project
🌿 Professional, reliable, and discreet
🌿 Serving Northeast Ohio and all surrounding counties, including Cuyahoga, Summit, Lake, Geauga, Portage, Medina, Lorain, and beyond.
Mold & Environmental Cleanup Services
Mold Testing
Identify hidden mold and measure indoor air quality with certified testing methods. Our detailed reports give you clarity on what’s affecting your home or business, helping you make informed decisions for a healthier environment. With Summit Environmental, you gain peace of mind through trusted, accurate results.
Mold Inspections
We provide comprehensive inspections of attics, basements, and entire properties to detect visible and hidden mold issues. Our experienced team communicates clearly about what we find and recommends tailored solutions. You can rely on us for thorough evaluations that protect your property and health.
Mold Remediation
Safe removal and treatment eliminate mold growth and prevent it from returning. We use proven techniques to restore your property while minimizing disruption. Choosing Summit Environmental means choosing a long-term solution that keeps your home or business safe, clean, and mold-free.
Hoarder House Cleanup
We handle hoarder home cleanups with discretion, compassion, and professionalism. Our team thoroughly cleans and sanitizes affected areas, restoring comfort and safety. Summit Environmental gives families and property owners a respectful solution that turns overwhelming situations into livable spaces again.
Environmentally Impacted Homes
From pet damage to contamination, our specialized cleanup services restore properties that have been environmentally impacted. We focus on safety, odor control, and deep cleaning, ensuring your space is healthy and comfortable once again. Clients trust us for reliable results and respectful service.
General Home Clean Outs
Whether preparing for a sale, rental, or transition, we provide efficient and thorough home clean outs. Our crew manages the heavy lifting, disposal, and final cleanup, saving you stress and time. With Summit Environmental, you can move forward knowing the job was handled professionally.